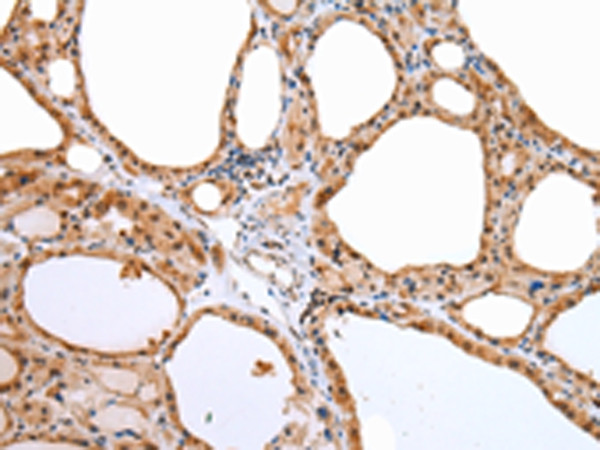
Aquaporin 9 Antibody in Immunohistochemistry (Paraffin) (IHC (P))

Search
Invitrogen
Aquaporin 9 Polyclonal Antibody
{{$productOrderCtrl.translations['antibody.pdp.commerceCard.promotion.promotions']}}
{{$productOrderCtrl.translations['antibody.pdp.commerceCard.promotion.viewpromo']}}
{{$productOrderCtrl.translations['antibody.pdp.commerceCard.promotion.promocode']}}: {{promo.promoCode}} {{promo.promoTitle}} {{promo.promoDescription}}. {{$productOrderCtrl.translations['antibody.pdp.commerceCard.promotion.learnmore']}}
产品信息
PA5-51285
已发表种属
宿主/亚型
分类
类型
抗原
偶联物
形式
浓度
规格
保存条件
运输条件
RRID
产品详细信息
The antibody detects endogenous levels of total Aquaporin 9 protein.
靶标信息
The aquaporins are a family of water-selective membrane channels. This gene encodes a member of a subset of aquaporins called the aquaglyceroporins. This protein allows passage of a broad range of noncharged solutes and also stimulates urea transport and osmotic water permeability. This protein may also facilitate the uptake of glycerol in hepatic tissue. The encoded protein may also play a role in specialized leukocyte functions such as immunological response and bactericidal activity. Alternate splicing results in multiple transcript variants.
仅用于科研。不用于诊断过程。未经明确授权不得转售。